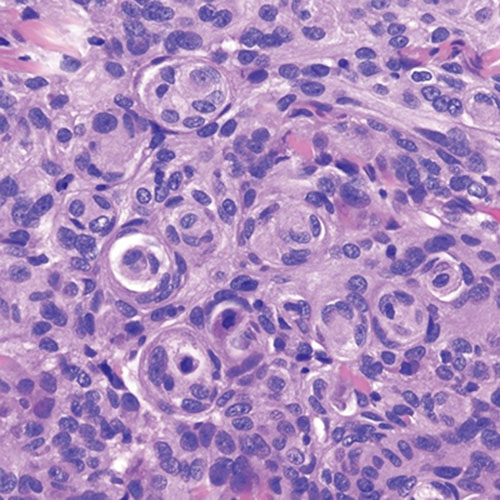
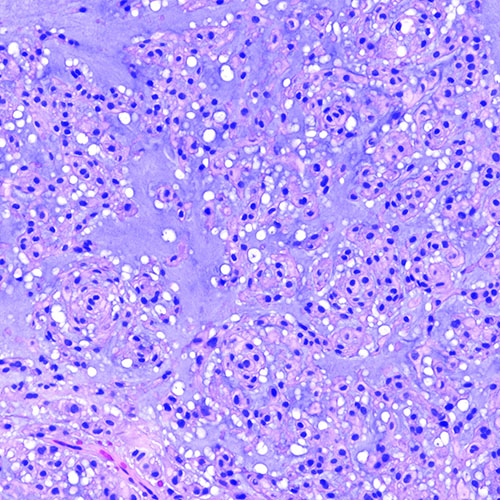

What Brain Tumors Look Like Under a Microscope
The Power of Pathology to Detect Disease
Updated October 2025
Pathology is the study of disease. Pathologists at Northwestern Medicine conduct more than 9 million reportable tests each year to monitor health status, diagnose diseases, determine disease progression, determine drug levels and measure response to treatment. These tests take many forms, from blood draws to tissue samples called biopsies.
Neuropathology is the study of diseases of the nervous system, which includes the brain.
“With surgical neuropathology, we take surgical biopsies obtained by our neurosurgery colleagues and determine diagnosis and tumor behavior” says Rudy Castellani, MD, a neuropathologist at Northwestern Medicine. “We can usually tell if the tumor is low-grade or malignant, what kind of cancer is present and the grade of the cancer. More recently, we can examine the tumor on the molecular level, which may open the door to different adjuvant therapies. It is a modern approach tailored to the individual patient’s treatment plan and not just the naming of a given tumor.”
A Closer Look
Tumors can look identical under the microscope but have very different prognoses depending on the person and their genetics.
Dr. Castellani is one of many physician-scientists at Northwestern Medicine who take patient-based bedside observations to the lab bench for further analysis. “We then can take what we discover in the lab and apply it back to the bedside to provide better care for our patients,” he says.
Here’s a look at some brain tumor tissue found under a microscope. See if you can pick out the patterns in these microscopic views, ranging from common to rare.
Schwannomas are benign tumors that arise in the peripheral nerves and can spread to the brain. They can cause pain and sometimes nerve damage but are nearly always noncancerous and usually do not grow back after surgery. They’re one of the only tumors whose cells form neatly arranged rows (palisades) and show areas of denser and looser architecture.

Meningioma tumors are characterized by distinctive pink whorls of cells. They arise in the membranes surrounding the brain and grow slowly. Roughly 90% of meningioma cases are low-grade, but many do grow back and may become resistant to radiation. Currently, no chemotherapy has proven effective against these tumors.
Metastatic cancer is the most common type of brain cancer. It spreads to the brain from another part of the body. Neuropathologists can determine where the tumor came from based on tumor cell patterns and other special tests. For example, metastatic cancer from the colon tends to form little glands within the brain filled with cellular debris, whereas metastatic cancer from the breast or lung may produce mucus that shows up as bluish-grey material between the cancerous glands.


Choroid plexus papillomas form in the choroid plexus, which is the area at the base of the brain where the fluid that cushions and protects the brain is made. They present as finger-like structures and are typically low-grade but can sometimes become aggressive. Even low-grade tumors can be lethal if they block the flow of this fluid, causing excessive pressure in the brain.

Chordomas occur in one out of one million people. The tumor cells form little bubble-like clusters and often produce a lot of cartilage-like material, seen as blue-grey areas within the tumor. They can form along the spine, invade local structures and even destroy the bones at the base of the skull or the spine. Even after surgical resection and radiation, these tumors usually keep growing back.
Glioblastoma is the most common and, unfortunately, the most malignant tumor that starts within the brain itself. Glioblastoma tumor cells spread throughout the brain so that complete surgical removal is not possible. Radiation and chemotherapy are used to slow the spread of the tumor; they do not cure the condition. More than 12,000 people are diagnosed with glioblastomas in the United States every year.

Analyzing a biopsy under the microscope is just one way physicians determine the diagnosis and prognosis of brain tumors.
“We can achieve great understanding of brain tumors and how to treat them by looking at these tiny patterns and structures on the microscopic level,” says Dr. Castellani. “Though seemingly behind the scenes, pathology is vital and necessary for patient treatment. It is pushing our treatment options forward, one step at a time.”






